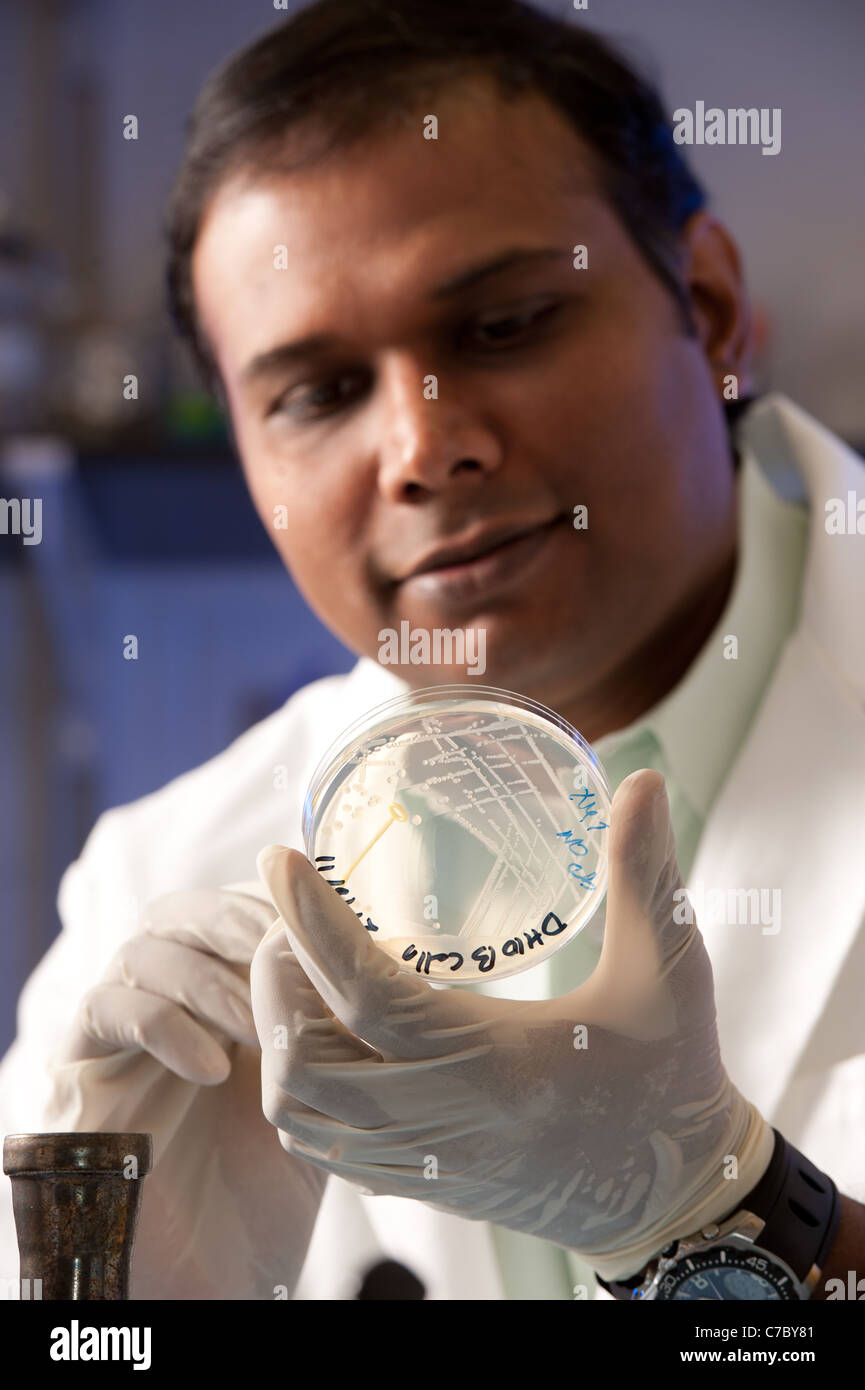
L'observation d'un scientifique petri dish Banque D'Images
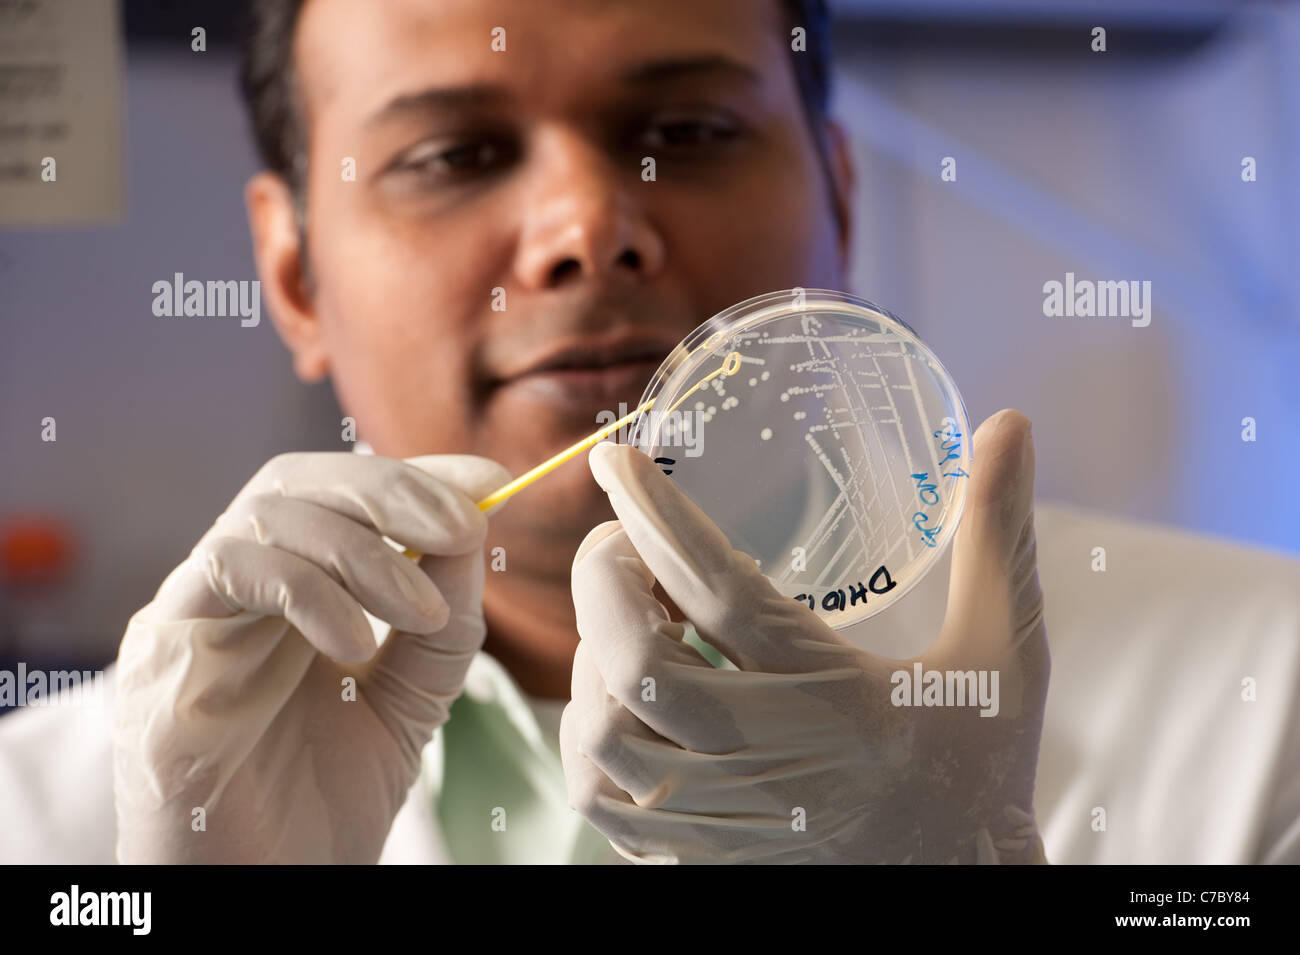
L'observation scientifique des cultures dans une boîte de Petri Banque D'Images

équipement de labo Photos Stock & Des Images
(73)équipement de labo Photos Stock & Des Images

RMEP0YAM–Femme scientifique de faire des expériences au laboratoire scientifique d'une usine de College Park, Maryland, USA

RMEP0Y02–Porte ouverte à une armoire pleine de microscopes dans une université de College Park, Maryland

RMEBGEJP–Chercheur scientifique à la pièce près de pine dans un laboratoire de diagnostic phytosanitaire